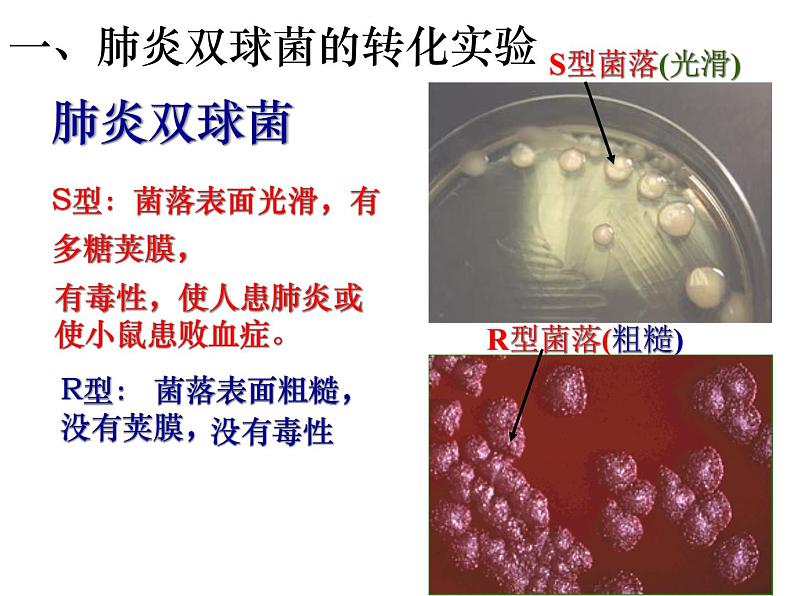

高中生物人教版 (2019)必修2《遗传与进化》第1节 DNA是主要的遗传物质授课ppt课件
展开作为遗传物质应具有的特点:
1、能够储存巨大数量的遗传信息2、结构具有稳定性3、可以准确地复制出拷贝,并进行传递
染色体=DNA+蛋白质
格里菲思的肺炎双球菌体内转化实验
艾弗里的肺炎双球菌体外转化实验
烟草花叶病毒的侵染实验
S型:菌落表面光滑,有多糖荚膜,
一、肺炎双球菌的转化实验
R型: 菌落表面粗糙,没有荚膜,
有毒性,使人患肺炎或使小鼠患败血症。
[过程探究1]体内转化实验——格里菲思等
结论: S型死菌中含有一种“转化因子”,能使R型菌转化为S型菌使小鼠致死。
[实验设计]寻找转化因子:
在杀死的S型细菌中含有哪些物质?
但究竟哪一个才是转化因子呢?
在证明DNA还是蛋白质或其他物质是遗传物质的实验中最关键的设计思路是什么?
必须将蛋白质、其他物质与DNA分开,单独、直接地观察它们的作用,才能确定究竟谁是遗传物质。
二、艾弗里确定转化因子的体外转化实验
实验结论:DNA才是使R型细菌产生稳定遗传变化的物质,也就是说,DNA才是遗传物质,蛋白质不是遗传物质。
艾弗里的实验引起了人们的注意,但是,不是所有的人都信服这一结果,因为实验中DNA纯度最高时也还有0.02%的蛋白质,所以有人对其结果表示怀疑。
1952年,赫尔希和蔡斯,完成了更有说服力的实验——噬菌体的侵染实验
三、噬菌体侵染细菌的实验
T2噬菌体(一种专门吸附在大肠杆菌上的病毒)放大25000倍
T2噬菌体是由头部和尾部组成的,头部和尾部的外壳由蛋白质组成,在头部内含有DNA分子。它是一种专门寄生在大肠杆菌体内的病毒,没有独立代谢能力。
三、噬菌体侵染细菌的实验 1952
T2噬菌体侵染细菌时,会吸附在大肠杆菌表面,在自身遗传物质的作用下,利用细菌体内的物质来合成自身的组成成分,从而进行大量的繁殖.
因为P几乎都存在于DNA中,而S仅存在于蛋白质中,所以用32P标记DNA,用35S标记蛋白质; 此实验不能标记C、H、O、N元素,因为DNA和蛋白质中都含有C、H、O、N元素。
制备含有放射性标记噬菌体
在分别含有放射性同位素32P 和35S的培养基中培养细菌
分别用上述细菌培养T2噬菌体,制备含32P的噬菌体和含35S的噬菌体
噬菌体侵染未标记的细菌
(一组用32 P标记DNA,一组用35S标记蛋白质)
1.蛋白质外壳进入,DNA未进入
2.蛋白质外壳未进入,DNA进入
1.蛋白质外壳和DNA都进入
在新生成的噬菌体中检测不到35S 。
在新生成的噬菌体中检测到了32P。
证明:DNA是遗传物质,蛋白质不是遗传物质。
四、烟草花叶病毒的侵染实验
烟草花叶病毒(简称TMV),它的基本成分就是蛋白质和RNA。
RNA是烟草花叶病毒的遗传物质
1957年,格勒和施拉姆
高中生物人教版 (2019)必修2《遗传与进化》第3章 基因的本质第1节 DNA是主要的遗传物质优质课ppt课件: 这是一份高中生物人教版 (2019)必修2《遗传与进化》第3章 基因的本质第1节 DNA是主要的遗传物质优质课ppt课件,文件包含人教版高中生物必修二31DNA是主要的遗传物质课件pptx、人教版高中生物必修二31DNA是主要的遗传物质含答案解析docx等2份课件配套教学资源,其中PPT共38页, 欢迎下载使用。
高中生物人教版 (2019)必修2《遗传与进化》第1节 DNA是主要的遗传物质图文ppt课件: 这是一份高中生物人教版 (2019)必修2《遗传与进化》第1节 DNA是主要的遗传物质图文ppt课件,共28页。PPT课件主要包含了蛋白质,脱氧核苷酸,脱氧核糖,可能蕴含着遗传信息,对DNA结构不了解,噬菌体侵染细菌的实验,两种菌落的比较,有多糖,R型活细菌,S型活细菌等内容,欢迎下载使用。
人教版 (2019)必修2《遗传与进化》第1节 DNA是主要的遗传物质备课ppt课件: 这是一份人教版 (2019)必修2《遗传与进化》第1节 DNA是主要的遗传物质备课ppt课件,共28页。PPT课件主要包含了蛋白质,脱氧核苷酸,脱氧核糖,可能蕴含着遗传信息,对DNA结构不了解,噬菌体侵染细菌的实验,两种菌落的比较,有多糖,R型活细菌,S型活细菌等内容,欢迎下载使用。